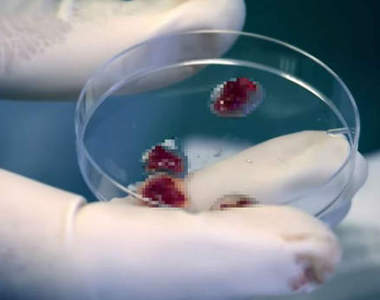
閱覽注意《用人肉做漢堡》這份人肉漢堡還要實驗者自己吃下......

意外嚇到人的《星巴克餅乾》該說這餅乾可愛還是血腥呢...
星巴克因應聖誕節的到來推出不少期間限定商品,除了有聖誕款的杯子可以讓顧客買回去使用,在輕食與甜點上也應景獻上聖誕版本,讓你用吃的方式過聖誕節(笑)。國外有網友發現這次聖誕節推出的星巴克餅乾乍看很可愛,...

血腥注意《怪物變裝達人》呼籲亞洲COSER要對自己有信心?
投入COSPLAY的玩家們,曾經因為自己掛著亞洲人的臉孔而覺得自卑嗎?許多人覺得歐美臉孔比較容易COSPLAY亞洲角色,而亞洲人扮起歐美角色的時候反而顯得非常不自然,不過善於扮妝成怪物的達人Icema...

《最過激血腥暴力遊戲 TOP 10》未成年絕對不能嘗試喔!
若要說歐美遊戲與日本遊戲最大的不同,應該就在於歐美有過度激烈的暴力遊戲了,暴力到進入日本都會被和諧掉,甚至在有些國家是被禁止發售的!!以下外國網站選出《最過激血腥暴力遊戲 TOP 10》絕對18禁,未...

《瘋狂的少女育成》超殘忍美少女血腥削腦game
不知道大家會不會這樣,壓力大的時候就會想要玩一下番茄醬噴很多的遊戲,意外的會很抒壓XD這一款手機遊戲《瘋狂的少女育成》(狂気のサイコパス育成)是一款真的很病很血腥的遊戲,但玩家養成的卻又是一位長相清秀...

【閱覽注意】《血腥冰雪奇緣》這次Elsa一樣是受人注目的主角......
前些天跟大家分享冰雪奇緣在2014締造的傳奇事蹟時,就想說裡面有Kuso類、Cosplay類、百合類、大亂鬥類等,但就是沒有血腥類的說(→是多愛看恐怖東西嚇自己)。不少人會在網路上自製翻外篇劇情,例如...

《都市傳傳說》想打破洗手台傳說的大學生決定在那裡洗手
有些傳說如果不是當地人也許不知道,所以不幸誤觸傳說的話,也可以說是很無辜。但如果有人是明明知道某個都市傳說,卻故意要去試試看的話,若是發生什麼事,也只能說是自己找的(攤手)。這次的都市傳說講的就是這種...